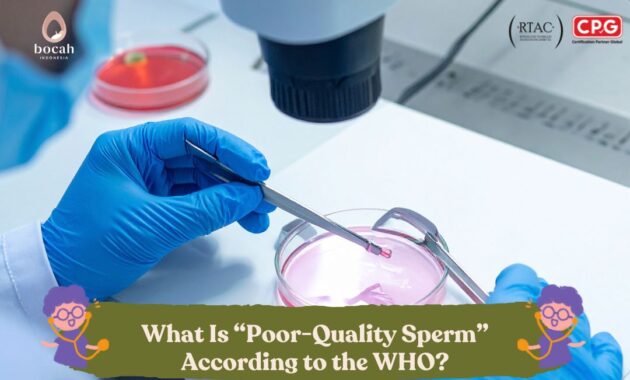

One of the key factors for successful fertilization is healthy sperm. There are several parameters used to determine whether sperm is healthy and of good quality.
What Is Meant by Poor-Quality Sperm?
The World Health Organization (WHO) has never officially used the term “poor-quality sperm.” This term is commonly used to describe sperm with low or abnormal quality, medically referred to as abnormal semen parameters.
However, the WHO has established specific indicators or criteria to assess whether sperm quality is considered normal. If one or more of these indicators fall below WHO standards, the sperm is classified as having abnormalities, which in everyday language is often referred to as “poor-quality sperm.”
Several conditions may contribute to reduced sperm quality, including:
-
Unhealthy lifestyle habits (e.g., smoking, alcohol consumption, overweight or obesity)
-
Infections or sexually transmitted diseases (STDs)
-
Exposure to chemicals or radiation
-
Varicocele
-
Ejaculatory disorders
-
Blockage of the testes or sperm ducts
-
Tumors or prostate cancer
-
Side effects of certain medications
-
Genetic factors
What Are the Criteria for Healthy Sperm According to the WHO?
The WHO defines several parameters in semen analysis to determine whether sperm quality is normal. The following are key WHO standards for normal sperm:
1. Sperm Count
One of the primary indicators of normal sperm is sperm concentration. A normal sperm count ranges from 15–20 million sperm per milliliter of semen. If the sperm concentration is lower than this range, it may indicate reduced sperm health and can affect fertility.
A lower sperm count decreases the likelihood of pregnancy compared to normal levels. If no sperm are present in the semen at all, this condition is known as azoospermia.
2. Sperm Morphology (Shape)
Another important indicator is sperm morphology. Normal sperm typically have an oval-shaped head and a long tail. Abnormal sperm may have defects such as misshapen heads, short, bent, or branched tails.
3. Sperm Motility (Movement)
Sperm motility refers to the ability of sperm to move effectively toward the egg. This movement is essential for fertilization. According to Dr. Androniko Setiawan, Sp.And, an andrology specialist at Bocah Indonesia, at least 30% of sperm should demonstrate progressive motility in order to reach the egg.
4. Sperm Viability (Live Sperm Count)
Viability refers to the percentage of live sperm in the semen sample. Sperm is considered normal if more than 54% of sperm are alive.
What Are the Effects of Poor-Quality Sperm?
Sperm that does not meet WHO criteria may increase the risk of several conditions, including:
How to Improve Sperm Quality and Maintain Sperm Health
To maintain healthy sperm quality and quantity, several lifestyle measures can be taken, such as:
-
Engaging in regular physical activity for at least 30 minutes per day
-
Maintaining an ideal body weight
-
Managing stress effectively
-
Avoiding activities that increase testicular temperature, such as prolonged cycling
Conclusion
The term “poor-quality sperm” refers to sperm that does not meet the minimum quality standards established by the WHO, whether in terms of count, morphology, motility, or viability. Various factors can contribute to reduced sperm quality, including lifestyle habits, chemical exposure, infections, and genetic factors.
One of the most effective ways to assess sperm health is through a semen analysis test, which evaluates sperm parameters in a semen sample. This examination helps determine whether a man’s sperm meets the WHO criteria. Let’s take the first step—have your sperm health checked today, Dad!
Source:
-
WHO Laboratory Manual for the Examination and Processing of Human Semen (6th Edition).
-
Mayo Clinic – Male Infertility: Symptoms & Causes.
-
Journal of Human Reproduction Update – WHO Reference Values.
-
Bocah Indonesia Medical Insights – Dr. Androniko Setiawan, Sp.And.